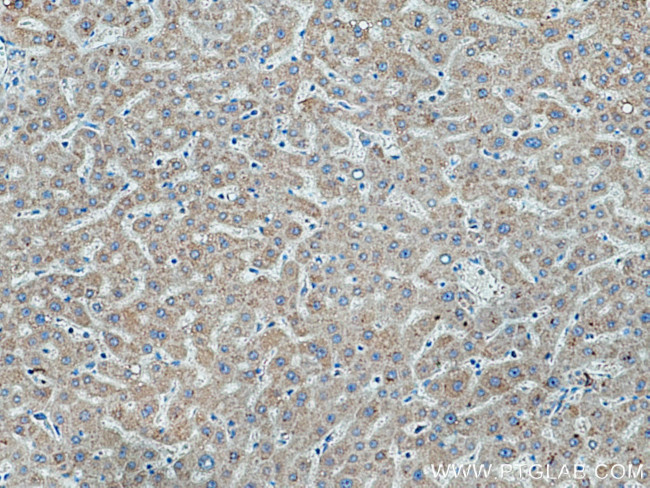
TMEM70 Antibody in Immunohistochemistry (Paraffin) (IHC (P))

Search
Proteintech
TMEM70 Polyclonal Antibody
{{$productOrderCtrl.translations['antibody.pdp.commerceCard.promotion.promotions']}}
{{$productOrderCtrl.translations['antibody.pdp.commerceCard.promotion.viewpromo']}}
{{$productOrderCtrl.translations['antibody.pdp.commerceCard.promotion.promocode']}}: {{promo.promoCode}} {{promo.promoTitle}} {{promo.promoDescription}}. {{$productOrderCtrl.translations['antibody.pdp.commerceCard.promotion.learnmore']}}
产品信息
20388-1-AP
种属反应
已发表种属
宿主/亚型
分类
类型
抗原
偶联物
形式
浓度
规格
纯化类型
保存液
内含物
保存条件
运输条件
产品详细信息
Immunogen sequence: MGSFTVITP VLLHFITKGY VIRLYHEATT DTYKAITYNA MLAETSTVFH QNDVKIPDAK HVFTTFYAKT KSLLVNPVLF PNREDYIHLM GYDKEEFILY MEETSEEKRH KDDK (148-260 aa encoded by B C002748)
靶标信息
TMEM70 is a recently identified mitochondrial protein that is thought to play a role in the biogenesis of the ATP synthase in higher eukaryotes. Mutations in this gene result in early neonatal onset of hypotonia, hypertrophic cardiomyopathy, lactic acidos and 3-methylglutaconic aciduria (3-MGC-uria), and usually cause death within the first six weeks of life, although some patients survive much longer. Little is known of the role of TMEM70, but it is conserved across multicellular eukaryotic organisms. It contains a conserved DUF1301 domain and two putative transmembrane regions.
仅用于科研。不用于诊断过程。未经明确授权不得转售。
生物信息学
蛋白别名: mitochondrial complex V deficiency, nuclear type 1; Transmembrane protein 70, mitochondrial; unnamed protein product
基因别名: MC5DN2; TMEM70
UniProt ID: (Human) Q9BUB7
Entrez Gene ID: (Human) 54968